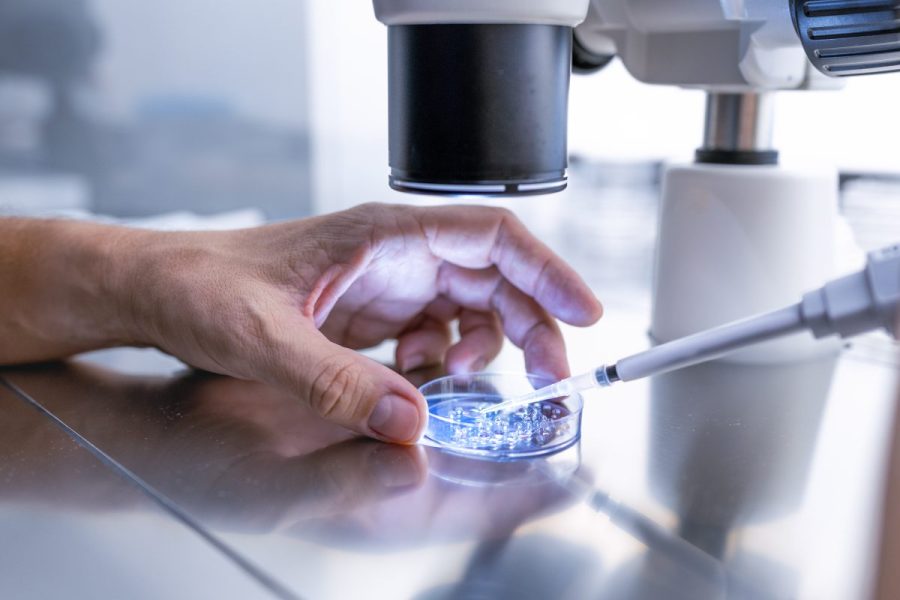

NORWALK, Connecticut (WTNH) — Uma clínica de fertilidade de Connecticut está conscientizando sobre a escassez de doadoras de óvulos negros, o que, segundo ela, está causando estresse para todas as raças que desejam ter filhos parecidos com elas.
Tomeeko Hunt, 49, se tornou mãe há menos de três meses.
Hunt diz que sempre quis ter filhos, mas estava muito focada em sua carreira como administradora escolar enquanto também concluía dois mestrados.
“Eu sabia que não queria ser mãe no meio da escola”, disse ela.
Hunt disse que, eventualmente, chegou a hora de ter um filho. Embora seu médico tenha dito que ela era saudável, ela decidiu recorrer à fertilização in vitro devido à sua idade e porque “não seria sensato para mim seguir o caminho natural”.
Hunt foi informada por seu médico que não seria fácil quando se tratasse de compatibilidade com um doador da mesma raça. Mas ela disse que foi “abençoada” por não ter enfrentado esses obstáculos e ter conseguido encontrar um doador que também era compatível com ela geneticamente bem rápido.
“Literalmente, em uma semana, eu já tinha feito a seleção e conseguido seguir em frente, mas sei que isso não é fácil para todos, especialmente para afro-americanos e latinos”, disse Hunt.
A experiência de Hunt contradiz a jornada de fertilização in vitro para muitas famílias de cor que estão tentando encontrar uma doadora de óvulos. As estatísticas mostram que elas normalmente têm muito poucas opções.
De acordo com a Egg Donor USA, apenas 15% dos 300 doadores em seu banco de dados foram identificados como negros. É uma história semelhante para doadores de esperma, com apenas 4% de seus doadores sendo negros, de acordo com dados do California Cyrobank.
Brooke Jones é uma das poucas doadoras de óvulos Black por aí. Ela passou por três ciclos, começando em 2017.
“Foi meu segundo ciclo”, disse Jones. “Tive a chance de falar com a família, e eles disseram, 'É, quando olhamos para esses livros, não vemos ninguém que se pareça conosco.'”
Jones disse que há uma série de razões pelas quais mais doadores não se parecem com ela.
“Existe esse estigma de mulheres negras não terem apoio ou não confiarem em ninguém na área da saúde”, disse ela.
Esse estigma existe há gerações, de acordo com o Dr. Mark Leondires, fundador e diretor médico da Illume Fertility.
“Se eles perguntarem aos mais velhos ou aos pais sobre isso, eles vão dizer: 'Não, eles vão levar todos os seus óvulos'”, disse Leondires. “Há também esse conceito de e se você doar seus óvulos, o que isso faz com sua árvore genealógica?”
Leondires disse que mulheres negras têm quase o dobro da taxa de infertilidade em comparação com mulheres brancas, tornando a demanda por doadores negros ainda maior. No entanto, ele disse que há uma necessidade geral de mais doadores de todas as raças, etnias e religiões.
“Todos esses nichos que nos ajudam a definir quem somos”, ele disse. “Parece confortável para eles e os ajuda a fazer essa mudança de não ter filhos para ser pais algum dia.”
Então, o que pode ser feito para incentivar mais pessoas de cor a se tornarem doadoras de óvulos?
Jones disse que a conscientização é o primeiro passo. Ela também encoraja as pessoas a fazerem suas próprias pesquisas e aprenderem com os próprios médicos sobre como podem ajudar outra família.